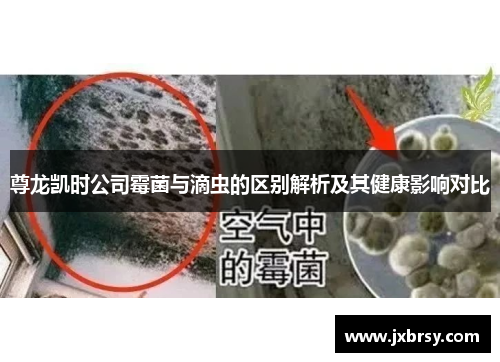
尊龙凯时公司霉菌与滴虫的区别解析及其健康影响对比 尊龙凯时公司霉菌与滴虫的区别解析及其健康影响对比

尊龙凯时公司霉菌与滴虫的区别解析及其健康影响对比
文章摘要:
霉菌与滴虫是两类不同的微生物,它们在生态环境中都发挥着重要作用,但在人体健康方面却有着显著差异。霉菌是一种真菌,其对人体的危害主要体现在引发过敏反应、呼吸道疾病及免疫系统的损害;而滴虫则是单细胞的寄生虫,主要通过性传播或水源传播,对生殖系统和泌尿系统健康构成威胁。本文将通过四个方面详细解析霉菌与滴虫的区别,并探讨它们各自对人体健康的不同影响。首先,我们将从它们的生物学特性入手,阐述二者的基本形态和生长环境;其次,分析它们传播途径的不同,进一步了解其传播方式及可能带来的健康风险;接着,比较它们对人体健康的不同影响,揭示各自引发的症状和疾病类型;最后,我们将探讨霉菌与滴虫的预防措施及治疗方法,为大众提供科学的健康指导。通过这些方面的解析,读者能够更加清晰地理解霉菌和滴虫的区别及其对人体健康的潜在威胁。
1、生物学特性:霉菌与滴虫的区别
霉菌和滴虫的生物学特性差异显著,主要体现在其分类、形态及生长环境上。霉菌属于真菌界,是由多细胞组成的微生物,通常在潮湿、温暖的环境中生长。它们通过孢子传播,能够在空气、水和土壤中广泛分布。霉菌通常呈现丝状或菌落状,其结构复杂,具有独立的营养获取和繁殖机制。而滴虫则是一种单细胞原生动物,属于鞭毛虫科,体型较小,形态上呈现单一的鞭毛状或椭圆形,能够利用鞭毛进行运动。滴虫主要通过其宿主的生殖道或消化道传播,生活在湿润的环境中,主要寄生在人类或其他动物体内。
霉菌的生长方式主要依赖于外部环境条件,如空气中的湿度、温度等,而滴虫则有明显的宿主依赖性。霉菌的孢子可以在空气中漂浮,通过呼吸被人体吸入,进而引发过敏性反应或呼吸道疾病;而滴虫通过性接触或污染水源传播,通常寄生在人体内的尿道或阴道等部位。由于霉菌生长迅速且繁殖能力强,其对环境的适应性很强,甚至能在极为恶劣的环境中生存。滴虫虽然在人体内也能迅速繁殖,但其生存依赖于特定的宿主条件,且只在一定的温度和湿度下才能存活。
此外,霉菌具有多样的种类和形态,常见的如青霉、曲霉等,它们在自然界中发挥着分解有机物的作用。滴虫则作为寄生生物,通常与宿主之间有着复杂的相互关系。虽然它们的生物学特性差异显著,但两者都对人体健康构成了不同的威胁。
2、传播途径:霉菌与滴虫的传播方式
霉菌与滴虫的传播途径存在明显差异,分别体现在空气传播和宿主传播上。霉菌的传播方式主要依赖空气中的孢子。它们在潮湿的环境中形成孢子,这些孢子随空气流动,进入人体时可能引发过敏性反应或导致呼吸道感染。特别是在空气湿度较高的环境下,霉菌孢子的数量会大幅增加,对人体健康构成潜在威胁。霉菌传播的风险主要集中在家庭、学校和办公场所等湿度较高的地方,尤其是霉变的墙壁、地毯、空气调节系统等。
相较于霉菌,滴虫的传播途径更加局限,主要依赖于直接的物理接触。滴虫通常通过性传播进行传播,也可以通过接触受到污染的水源而感染。滴虫的生长和繁殖需要依赖宿主的生殖系统,因此其传播大多发生在性接触频繁的人群中,尤其是在卫生条件较差的环境中,滴虫的传播风险会更高。此外,滴虫也能通过共用公共卫生设施,如不洁的游泳池或浴池,导致交叉感染。
AG8亚洲国际游戏集团总体而言,霉菌的传播较为广泛,几乎任何有湿度的环境都可能成为霉菌的滋生地,而滴虫则通过特定的传播途径传播,其传播范围和感染条件更为有限。霉菌传播的广泛性和普遍性,使得其防控难度较大;而滴虫的传播方式较为直接,通过改变生活习惯和提高卫生意识能够有效减少其传播风险。
3、健康影响:霉菌与滴虫对人体的危害
霉菌与滴虫对人体健康的影响各自独立且不同。霉菌引起的健康问题主要表现在过敏反应、呼吸道疾病和免疫系统的损害上。常见的霉菌过敏症状包括咳嗽、打喷嚏、眼睛发痒等,长期暴露在霉菌环境中还可能导致哮喘等慢性呼吸道疾病。对于免疫系统较弱的个体,霉菌孢子可能通过呼吸道或皮肤进入体内,引发更为严重的感染,甚至导致系统性真菌感染。
此外,霉菌感染还可能对皮肤、眼睛等部位造成直接损害。霉菌通过孢子在皮肤上扩散,可能引发皮肤炎症和过敏反应,特别是在湿疹、湿疣等皮肤病的患者中更容易发生。这类过敏症状虽然通常较为轻微,但长期接触可能会引发更严重的健康问题。
相比之下,滴虫对人体健康的影响主要集中在生殖系统和泌尿系统方面。滴虫感染常常引发阴道炎、尿道炎等疾病,典型症状包括分泌物增多、尿频尿急、下腹疼痛等。若不及时治疗,滴虫感染可能引起不孕不育等严重后果。滴虫也有可能引发更为严重的并发症,如盆腔炎等,甚至会影响到整个生殖系统的健康。
4、预防与治疗:霉菌与滴虫的防控措施
霉菌的预防措施主要集中在改善居住环境的湿度控制和空气流通上。定期清洁房屋,尤其是厨房、浴室等容易潮湿的地方,可以有效减少霉菌的滋生。此外,使用空气净化器和湿度控制设备,保持室内空气干燥,也是预防霉菌传播的重要措施。对于霉菌引发的健康问题,常见的治疗方法包括使用抗真菌药物,针对过敏性反应则可使用抗组胺药物和类固醇类药物来缓解症状。
滴虫的预防主要依赖于良好的个人卫生习惯。避免不洁的性行为是最有效的预防措施,使用避孕套可以大大减少滴虫的传播风险。此外,保持生殖器的清洁和干燥,避免共用浴巾、浴池等公共设施,也是防止滴虫感染的重要手段。滴虫感染的治疗通常需要使用抗滴虫药物,如甲硝唑或替硝唑等,治疗过程中要注意避免性接触,以防感染的再次传播。
总体来看,霉菌和滴虫的预防和治疗各有侧重,霉菌的防控更注重环境卫生,而滴虫的防控则强调个人卫生和性健康。无论是霉菌还是滴虫,采取科学有效的预防措施,都能够有效降低其对人体健康的威胁。
总结:
通过本文的分析,
发表评论